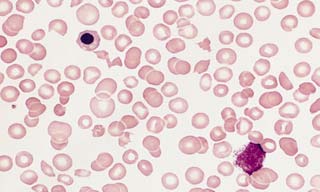
фото 2

Роль в организме
Хотя более 65% людей хотя бы раз проходили анализ на содержание тромбоцитов, не все осознают их роль в организме. В медицинской терминологии тромбоциты известны как кровяные пластинки, и их главная функция заключается в обеспечении быстрого свертывания крови.
Когда капилляр повреждается, тромбоциты способствуют образованию сгустка, который закрывает рану, тем самым останавливая кровотечение. Количество этих клеток напрямую влияет на скорость остановки крови при порезах и царапинах. Уровень тромбоцитов определяется в рамках общего анализа крови.
Низкий уровень тромбоцитов у ребенка вызывает серьезные опасения у врачей. Специалисты отмечают, что тромбоциты играют ключевую роль в процессе свертывания крови, и их недостаток может привести к повышенному риску кровотечений. Врачи подчеркивают, что причины тромбоцитопении могут быть разнообразными: от инфекций и аутоиммунных заболеваний до наследственных нарушений. Важно провести тщательное обследование, чтобы определить источник проблемы. Врачам также известно, что в некоторых случаях низкий уровень тромбоцитов может быть временным и не требовать серьезного вмешательства. Однако в других ситуациях может потребоваться лечение, включая медикаментозную терапию или даже переливание тромбоцитов. В любом случае, наблюдение и консультация с педиатром являются необходимыми для обеспечения здоровья ребенка.
https://youtube.com/watch?v=kJk61oFHqTk
Норма
Количество тромбоцитов у детей меняется в зависимости от их возраста. У новорожденных этот показатель колеблется в пределах от 100 до 420X10⁹/л, однако после достижения 12 месяцев он составляет от 150 до 350X10⁹/л.
Для годовалого ребенка уровень тромбоцитов считается нормальным, если он находится в диапазоне от 180 до 350X10⁹/л.
| Причина низкого уровня тромбоцитов | Симптомы | Возможные осложнения |
|---|---|---|
| Увеличение разрушения тромбоцитов (иммунная тромбоцитопеническая пурпура (ИТП), лекарственная тромбоцитопения) | Легкие или отсутствующие кровотечения (синяки, кровотечение из носа), петехии (мелкие красные пятна на коже), пурпура (большие синяки) | Кровотечение, внутреннее кровотечение, анемия |
| Уменьшение производства тромбоцитов (апластическая анемия, лейкемия, врожденные нарушения) | Как правило, те же, что и при увеличенном разрушении, но могут быть и другие симптомы, связанные с основным заболеванием (например, усталость, бледность при анемии) | Кровотечение, инфекции (при апластической анемии), онкологические осложнения (при лейкемии) |
| Разрушение тромбоцитов в селезенке (гиперспленизм) | Как правило, те же, что и при увеличенном разрушении, увеличение селезенки может быть пальпируемо | Кровотечение, инфекции |
| Другие причины (инфекции, дефицит витаминов, сепсис) | Разнообразные симптомы, зависящие от основной причины, может быть лихорадка, сыпь | Зависит от основной причины |
Классификация патологии
В международной практике медицины выделяют четыре степени тромбоцитопении как у детей, так и у взрослых:
- легкая степень, при которой уровень тромбоцитов составляет от 75 до 100X10⁹/л;
- умеренная степень (от 50 до 74);
- степень средней тяжести (от 20 до 49);
- тяжелая степень (менее 20).
При значительном снижении показателей симптомы будут выражены достаточно ярко. В случаях, когда у пациента диагностируется начальная или умеренная форма заболевания, клинические проявления могут быть практически незаметными. Обычно на этих стадиях заболевание обнаруживается случайно.
Низкий уровень тромбоцитов у ребенка вызывает беспокойство как у родителей, так и у врачей. Многие родители отмечают, что столкнувшись с этой проблемой, они начинают искать информацию и советы в интернете, обсуждая свои переживания на форумах. Часто звучат истории о том, как низкий уровень тромбоцитов проявляется в виде синяков, частых носовых кровотечений или усталости. Врачебные рекомендации могут варьироваться от наблюдения за состоянием до назначения дополнительных анализов и лечения. Родители делятся опытом, как важно следить за симптомами и не игнорировать их. Некоторые находят поддержку в группах, где обсуждаются методы повышения уровня тромбоцитов и общие рекомендации по питанию и образу жизни. Важно помнить, что каждый случай индивидуален, и консультация с врачом остается ключевым шагом в решении этой проблемы.
https://youtube.com/watch?v=_ceAbFG-E3I
Основные причины недуга
Медицинские специалисты утверждают, что в большинстве случаев пониженное количество тромбоцитов у детей является временным явлением, которое может быть вызвано неблагоприятными условиями окружающей среды или несбалансированным питанием. Однако иногда недостаток тромбоцитов может указывать на наличие серьезного заболевания.
По этой причине важно, чтобы врач провел полное обследование, включая различные анализы, которые помогут определить, что стало причиной нарушения. Низкий уровень тромбоцитов у детей может быть вызван следующими факторами:
- Нарушение работы костного мозга. Это может быть связано с лейкемией, свинкой или применением препаратов, замедляющих рост атипичных раковых клеток.
- Тромбоцитопеническая пурпура. При этом заболевании организм начинает вырабатывать антитела к тромбоцитам, воспринимая их как чуждые клетки.
- Увеличение селезенки, которое чаще всего наблюдается при гепатите или циррозе печени.
- Аллергические реакции на пищу или внешние раздражители. Особенно опасны реакции, возникающие после длительного приема определенных медикаментов.
- Наличие инфекционных заболеваний.
- Аутоиммунные расстройства.
- Запущенные формы аритмии.
- Туберкулез легких.
- Нарушения в работе эндокринной системы.
- Метастазы в костный мозг.
- Отравление токсическими веществами.
- Наличие паразитов в организме.
- Недостаток витамина B12 (кобаламина).
- Передача антител от матери к ребенку через плаценту. Этот фактор часто приводит к тромбоцитопении у новорожденных.
Симптоматика
Определить пониженное количество тромбоцитов у новорожденного можно по характерным признакам. Наиболее распространенным симптомом являются мелкие высыпания на коже. При снижении уровня тромбоцитов у ребенка могут возникать носовые кровотечения и повышенная склонность к кровоточивости десен.
К числу других симптомов относятся:
- моча может приобретать красноватый или розоватый оттенок;
- на теле ребенка могут появляться синяки даже от легких прикосновений;
- частые головные боли;
- возможна рвота с примесью крови;
- каловые массы могут становиться черными;
- при порезах кровь может долго не останавливаться.
Первичная тромбоцитопения проявляется иначе. Это аутоиммунное заболевание, причины которого до сих пор не установлены. Чаще всего оно встречается у детей в возрасте от 2 до 6 лет и может развиваться после перенесенного вирусного заболевания или вакцинации.
Заболевание прогрессирует быстро и сопровождается следующими симптомами:
- на коже появляются петехии и экхимозы различных размеров и форм;
- пятна на теле могут иметь разнообразную окраску – от фиолетового до зеленоватого;
- высыпания возникают внезапно;
- из-за кровоизлияний в сетчатку глаз у малыша могут наблюдаться постоянные покраснения глаз.
При остром течении болезни нельзя исключать риск кровотечения из желудочно-кишечного тракта.
https://youtube.com/watch?v=s7SbGMQkpts
Что означает снижение показателя
Снижение среднего объема тромбоцитов может указывать на наличие серьезных заболеваний. Для обеспечения здоровья ребенка врачам необходимо провести комплексное обследование, которое позволит определить, какое именно заболевание вызывает это нарушение.
Если лечение не будет начато вовремя, могут возникнуть серьезные последствия:
- Кровоизлияния в внутренние органы.
- Значительная потеря крови при травмах.
- Постоянные кровоизлияния в сетчатку могут привести к ухудшению зрения.
- Кровоизлияние в мозг может стать причиной летального исхода.
Не менее опасным является тромбоцитоз (увеличение количества тромбоцитов), и обе эти патологии требуют незамедлительного вмешательства.
Диагностика
При появлении симптомов болезни необходимо незамедлительно обратиться к врачу. Надежные данные о количестве тромбоцитов можно получить с помощью общего анализа крови.
Для получения точных результатов анализ следует сдавать натощак, лучше всего утром.
Крайне важно, чтобы ребенок не подвергался физическим и эмоциональным нагрузкам. Если результаты анализа вызывают сомнения, врач может назначить дополнительные исследования на свертываемость крови.
Способы лечения
Выбор схемы лечения следует осуществлять после установления причины заболевания. Для более быстрого восстановления уровня кровяных телец необходимо применять комплексный подход.
Медикаменты
Увеличить уровень тромбоцитов можно с помощью применения препаратов следующих фармацевтических групп:
-
Иммуноглобулины. Эти средства доступны в виде растворов для внутривенного введения. Их положительное воздействие обусловлено тем, что активные вещества взаимодействуют с антигенами и способствуют их уничтожению, что, в свою очередь, ускоряет процесс выработки тромбоцитов. Дозировка и продолжительность терапии определяются врачом.
-
Кортикостероиды. Эти препараты регулируют функции надпочечников с помощью гормонов. В результате нормализуется работа костного мозга, что приводит к активизации производства тромбоцитов.
-
Переливание тромбоцитарной массы. Данная процедура применяется в исключительных случаях, когда заболевание находится на запущенной стадии и существует угроза для жизни пациента.
Лечебное питание
Ключевым шагом в борьбе с заболеванием является изменение питания. Для повышения уровня тромбоцитов у ребенка важно обеспечить правильное и сбалансированное питание. Следует исключить из рациона продукты, которые могут ухудшить состояние:
- продукты с канцерогенами;
- фастфуд;
- цитрусовые (апельсины, мандарины, грейпфруты) и соки на их основе;
- изделия с высоким содержанием жиров;
- жареные и копченые блюда;
- ананасы.
В меню ребенка стоит добавить нежирное мясо (предпочтительно говядину), перепелиные яйца, а также морскую и речную рыбу. В качестве гарнира лучше использовать гречку, рис или фасоль, обогащенные зеленью. Вместо чая рекомендуется пить натуральные овощные соки или минеральную воду.
Народные способы
Одним из самых эффективных народных методов борьбы с тромбоцитопенией является использование сока крапивы. Рекомендуется давать ребенку смесь, состоящую из равных частей крапивного сока и молока (соотношение 1:1). Принимать это средство следует три раза в день за полчаса до приема пищи.
Также стоит отметить положительное влияние кунжутного масла. Однако перед началом лечения важно проконсультироваться с врачом, чтобы избежать возможных осложнений.
Специфика лечения новорожденных
Основная цель врачей заключается в предотвращении возникновения осложнений. В случае иммунных форм заболевания новорожденному рекомендуется:
- в течение первых трех недель получать донорское молоко, после чего возможно введение материнского молока (с учетом контроля уровня тромбоцитов);
- проводить внутривенное введение иммуноглобулинов;
- использовать аскорбиновую кислоту и рутин.
При тяжелой форме заболевания может потребоваться переливание тромбоцитарных масс.
Профилактика
Предотвратить возникновение тромбоцитопении невозможно, поэтому главная цель профилактических мероприятий заключается в предотвращении рецидивов. Рекомендуется следовать следующим рекомендациям:
- минимизировать вероятность травм и повреждений кожи;
- избегать физических нагрузок;
- соблюдать сбалансированное питание.
Снижение уровня тромбоцитов у ребенка требует внимательного отношения. При появлении первых симптомов заболевания необходимо обратиться к врачу и пройти соответствующие анализы. После этого будет назначено необходимое лечение.
Вопрос-ответ
Почему у детей снижается уровень тромбоцитов?
Тромбоцитопению у детей могут вызывать многие факторы, чаще всего — инфекции (особенно вирусные) и разрушение тромбоцитов иммунной системой (иммунная тромбоцитопения или ИТП).
Какой уровень тромбоцитов опасен для ребенка?
«Тромбоцитоз у детей – не редкость, и чаще всего он связан с инфекцией или дефицитом железа. Но если уровень тромбоцитов очень высокий (более 600–700 ×10³/мкл), это может указывать на серьезные проблемы, включая заболевания крови. Поэтому важно не откладывать визит к врачу.»
Советы
СОВЕТ №1
Обратитесь к врачу для диагностики. Низкий уровень тромбоцитов может быть признаком различных заболеваний, поэтому важно провести полное медицинское обследование, чтобы выяснить причину и получить соответствующее лечение.
СОВЕТ №2
Следите за симптомами. Обратите внимание на любые изменения в состоянии ребенка, такие как синяки, кровотечения или частые инфекции. Эти симптомы могут указывать на более серьезные проблемы и требуют немедленного обращения к врачу.
СОВЕТ №3
Обеспечьте сбалансированное питание. Включите в рацион ребенка продукты, богатые витаминами и минералами, такими как фрукты, овощи, орехи и цельнозерновые. Это поможет поддерживать здоровье и укрепить иммунную систему.
СОВЕТ №4
Избегайте травм и падений. Если у вашего ребенка низкий уровень тромбоцитов, важно минимизировать риск травм, так как это может привести к серьезным последствиям. Обеспечьте безопасную среду для игры и занятий спортом.